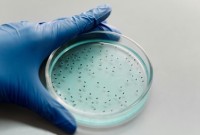
Anticoncepcional masculino injetável pode chegar ao mercado até 2028

Últimas Notícias
- Dionísio Cerqueira - Pela segunda vez, acusado de feminicídio triplamente qualificado tentado é absolvido pelo Tribunal do Júri
- Palma Sola - Programa Estrada Boa põe fim à espera e asfalta toda a SC-161 após décadas
- Dionísio Cerqueira - Jovens ficam feridos em batida entre moto e ônibus
- Paraná - Avô encontra adolescente de 15 anos morto ao lado da cama e celular é apreendido pela polícia
- Santa Catarina - Programa de habitação deve investir R$ 466 milhões em 32 municípios de SC
- Loterias - Mega-Sena não tem acertador; prêmio vai a R$ 25 milhões
- Paraná - Homem condenado por matar a ex-cunhada e ferir a ex-esposa é preso pela Polícia
- Nova Lei - Vereadores de cidade no norte do Paraná aprovam pagamento de R$ 1 mil para morador que denunciar crimes
- Trânsito - Três pessoas, entre elas uma criança, morrem após colisão frontal na BR-282
- Fatalidade - Identificadas as cinco vítimas de acidente registrado na PRC-158
- Tri-Fronteira - ASCOAGRIN realiza assembleia para rerratificação do estatuto e reunião de diretoria
- “Família, Pero No Mucho” - Nova comédia familiar com Leandro Hassum
- Brasil - Filme japonês estreia nos cinemas
- Francisco Beltrão - Retro escavadeira da prefeitrura atinge quatro veículos na área central
- Curiosidades sobre Naruto: - O que significam os gestos e selos de mão dos ninjas?
Eventos
Dionísio Cerqueira
Abertura do futsal reúne bom público
Dionísio Cerqueira